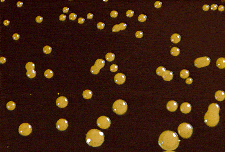
- Colonies ofCryptococcus neoformansin birdseed agar

Bird Seed Agar, also known as Staib medium, is a selective and differential medium for isolation of Cryptococcus neoformansfrom clinical specimens and differentiation of it from other Cryptococcus species. It is also known as caffeic acid agar or niger seed agar. Due to the presence of phenoloxidase enzyme, Cryptococcus species can utilize various phenolic compounds as their substrate and produce dark brown, melanin-like pigments, thus presumptively identified.
In 1966, Shields and Ajello modified Staib’s bird seed agar by making the medium selective with an antimicrobial additive.
Principle
The extract of Guizotia abyssinica seeds contains caffeic acid. Phenoloxidase enzyme produced by Cryptococcus neoformans utilizes caffeic acid as a substrate and produces melanin which in turn is absorbed by the yeast cell wall forming a tan to reddish-brown pigmentation. Glucose is the energy source in the medium. Creatinine enhances melanization of some strains of Cryptococcus neoformans. Agar is the solidifying agent. Chloramphenicol is added to inhibit the growth of bacteria and fast-growing fungi.
Composition
| Ingredients | Gm / Litre |
|---|---|
| Guizotia abyssinica seeds | 70g |
| Creatinine | 0.780g |
| Dextrose | 10g |
| Chloramphenicol | 0.050g |
| Agar | 20g |
| Final pH ( at 25°C) 6.7±0.2 |
Procedure for
preparation of media:
- Suspend required quantity (as per manufacturer’s instruction) of powder media in 1 liter of distilled water.
- Heat to boiling to dissolve the medium completely.
- Sterilize by autoclaving at 15 lbs pressure (121°C) for 15 minutes.
- Cool to 45°C and add 100 mcg diphenyl per ml of medium (1 ml of sterile 1% w/v aqueous solution of diphenyl).
- Mix well and pour into sterile Petri plates.
NOTE: The composition and method for media preparation vary according to the manufacturer. Some media contain pre-added phosphate and other antibiotics like penicillin G, gentamicin, while others need supplements to be added.
Interpretation of
results:
Plates inoculated with suspected samples are observed after incubation at 30°C for 2 weeks. The presence of golden brown to black pigmented smooth colonies is indicative of Cryptococcus neoformans. Other species like Cryptococcus laurentii, Saccharomyces cerevisiae, etc produce non-pigmented colonies. Candida appears as white colonies.
Uses
Bird Seed Agar is used for the selective isolation of Cryptococcus neoformans and Cryptococcus gattii.
Quality control
- Cryptococcus neoformansATCC 32045 can be used as a positive control that shows brown to black pigmented colonies.
- Escherichia coli ATCC 25922 can be used as a negative controlin which growth is inhibited partially or completely.
References and further readings
- Acharya T., Hare J. (2022) Sabouraud Agar, and Other Fungal Growth Media. In: Gupta V.K., Tuohy M. (eds) Laboratory Protocols in Fungal Biology. Fungal Biology. Springer, Cham. https://doi.org/10.1007/978-3-030-83749-5_2